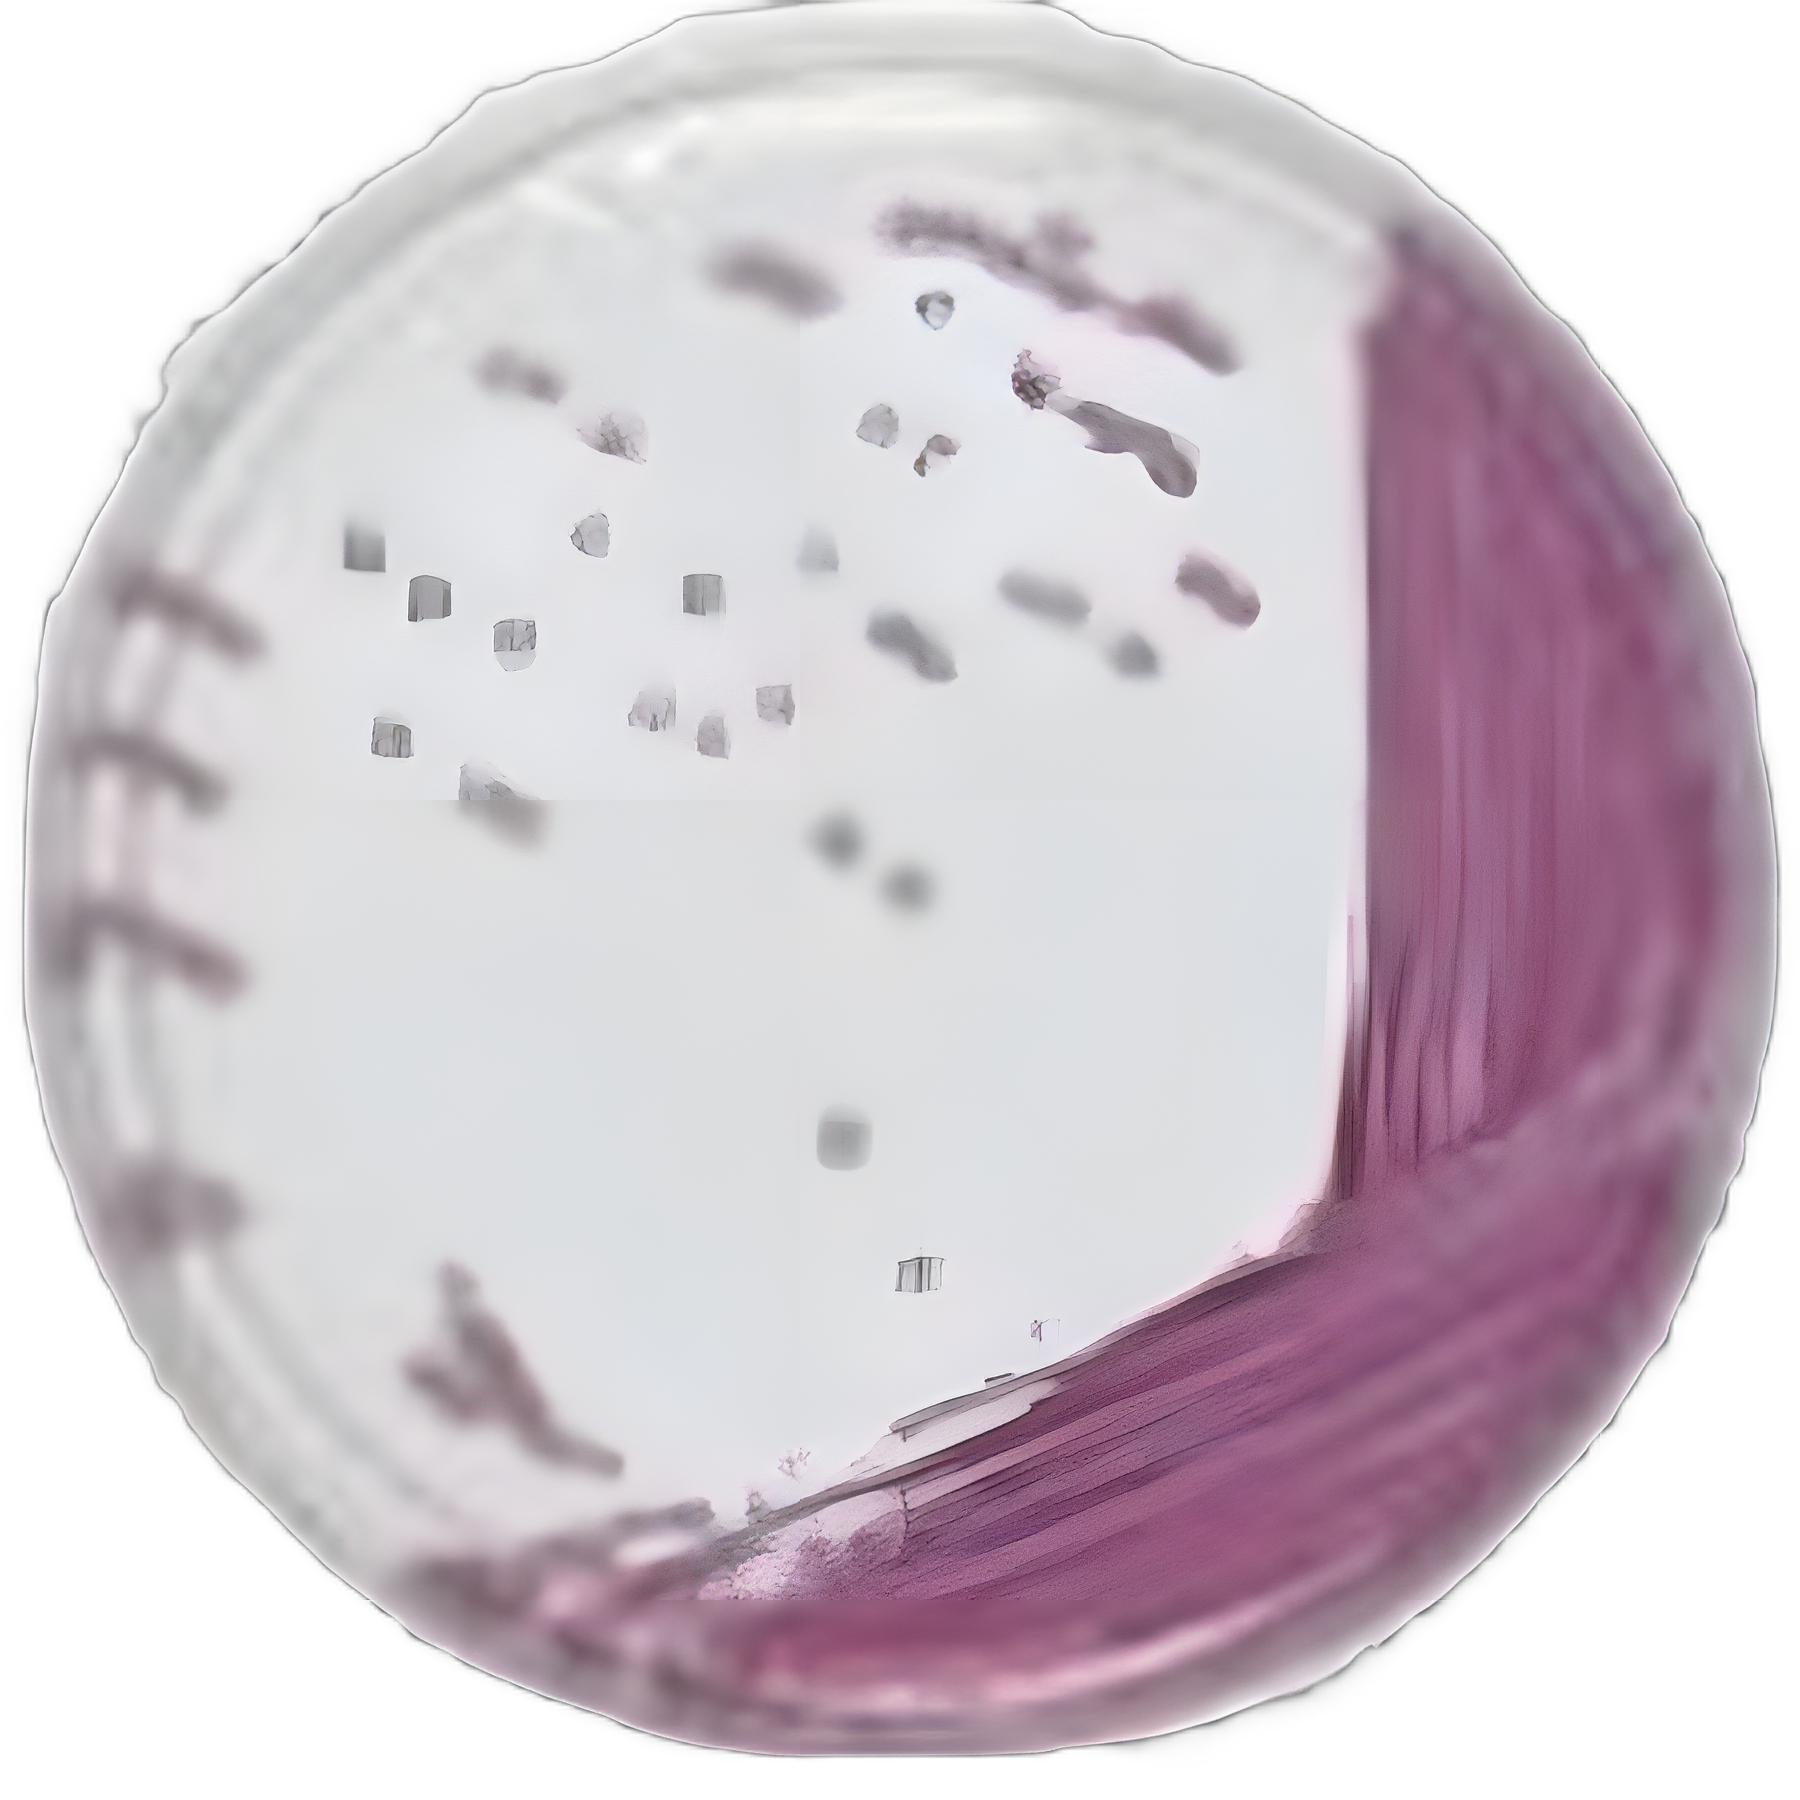

chromID Chromogenic Media Mono-Plate for Salmonella Isolation - 43621
43621 | USAMP#11059388
dimensions
Secure Checkout
Verified Supply Chain
Priority Fulfillment
More Information
Locked
Base Price
$137.75
BX
🎯 Unlock Your Custom Tiered Price
15-35% bulk discounts
100+
units
10% OFF
$XX.XX
per unit
Save $XXX
Payment Terms
Priority Shipping
Custom Contract Pricing
250+
units
20% OFF
$XX.XX
per unit
Save $XXX
Payment Terms
Priority Shipping
Custom Contract Pricing
500+
units
30% OFF
$XX.XX
per unit
Save $XXX
Payment Terms
Priority Shipping
Custom Contract Pricing
Unlock Bulk Pricing
See pricing for all volume tiers
Instant access to volume pricing. Register free to compare all tiers and calculate your exact savings.
5,000+ verified buyers
Average savings:$23,400/year
15-35% OFF
for healthcare facilities on bulk orders
24/7 Live Chat!
Instant support anytime
Product Spotlight
- Optimized with three chromogenic substrates for selective isolation and differentiation of Salmonella serotypes, including typhi, paratyphi, and most lactose-positive variants.
- Enhanced nutrient capacity boosts color intensity, improving sensitivity and specificity in detection.
- Effectively inhibits Gram-positive bacteria, yeasts, and the majority of non-fermenting Gram-negative bacteria.
- Ideal for fecal culture procedures, ensuring accurate results.
- Fully compatible with VITEK® 2 automated identification systems, streamlining laboratory workflows.